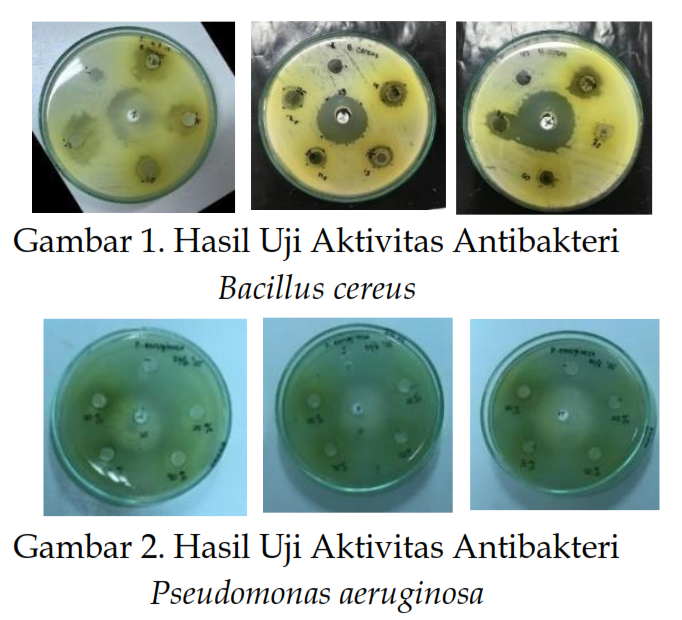

Download
Vol. 14 No. 2 (2025): Oktober

JURNAL BIOSHELL is a scientific journal of the Biology Education Study Program, Faculty of Teacher Training and Education, Islamic University of Jember which has been registered with the numbers ISSN 2301-4105 (print) and ISSN 2623-0321 (online). The scope of the JURNAL BIOSHELL is focused on research or literature reviews on biology education, biological science and natural science education. This issue has been available online since June 30, 2025, for the regular issue of October 2025. There are 12 research articles in this issue.
Articles
-
Pandangan Masyarakat terhadap Imunisasi pada Anak Usia 0-12 Bulan di Wilayah Kerja Aceh Singkil
 DOI :
https://doi.org/10.56013/bio.v14i2.3995
DOI :
https://doi.org/10.56013/bio.v14i2.3995
 Abstract View: 721,
Abstract View: 721,
 PDF Download: 1197
PDF Download: 1197
-
Strategi Ketercapaian Imunisasi di Pusat Pelayanan Pembantu Pegagan Julu III Kabupaten Dairi
 DOI :
https://doi.org/10.56013/bio.v14i2.3999
DOI :
https://doi.org/10.56013/bio.v14i2.3999
 Abstract View: 391,
Abstract View: 391,
 PDF Download: 590
PDF Download: 590
-
Efektivitas Media Video Berbasis PjBL untuk Meningkatkan Pemahaman Konsep Siswa pada Materi Tata Surya
 DOI :
https://doi.org/10.56013/bio.v14i2.4041
DOI :
https://doi.org/10.56013/bio.v14i2.4041
 Abstract View: 369,
Abstract View: 369,
 PDF Download: 275
PDF Download: 275
-
The Effect of Pangasius hypopthalmus Oil on the Memory of Mice (Mus musculus)
 DOI :
https://doi.org/10.56013/bio.v14i2.4330
DOI :
https://doi.org/10.56013/bio.v14i2.4330
 Abstract View: 278,
Abstract View: 278,
 PDF Download: 221
PDF Download: 221
-
Hubungan Pengetahuan dan Kepatuhan Cuci Tangan terhadap Kejadian Demam Tifoid di Kabupaten Tulungagung
 DOI :
https://doi.org/10.56013/bio.v14i2.4572
DOI :
https://doi.org/10.56013/bio.v14i2.4572
 Abstract View: 578,
Abstract View: 578,
 PDF Download: 681
PDF Download: 681
-
Efektivitas Media Tanam terhadap Pertumbuhan Tapak Dara (Catharanthus roseus L.)
 DOI :
https://doi.org/10.56013/bio.v14i2.4064
DOI :
https://doi.org/10.56013/bio.v14i2.4064
 Abstract View: 788,
Abstract View: 788,
 PDF Download: 432
PDF Download: 432
-
Pemanfaatan Ekoenzim dari Limbah Kulit Nanas dan Jeruk sebagai Disinfektan Alami
 DOI :
https://doi.org/10.56013/bio.v14i2.4612
DOI :
https://doi.org/10.56013/bio.v14i2.4612
 Abstract View: 1796,
Abstract View: 1796,
 PDF Download: 1232
PDF Download: 1232
-
Efek Toksik Logam Berat terhadap Kejadian Stunting
 DOI :
https://doi.org/10.56013/bio.v14i2.4577
DOI :
https://doi.org/10.56013/bio.v14i2.4577
 Abstract View: 338,
Abstract View: 338,
 PDF Download: 370
PDF Download: 370
-
Analisis Persepsi Siswa MTs S Al Makmur Palangka Raya terhadap Problem Box sebagai Media Pembelajaran Non Digital
 DOI :
https://doi.org/10.56013/bio.v14i2.4827
DOI :
https://doi.org/10.56013/bio.v14i2.4827
 Abstract View: 220,
Abstract View: 220,
 PDF Download: 146
PDF Download: 146
-
Analisis Kebutuhan Pengembangan LKPD Berbasis Problem Based Learning Bernuansa Kontekstual pada Materi Bioteknologi untuk SMA
 DOI :
https://doi.org/10.56013/bio.v14i2.4839
DOI :
https://doi.org/10.56013/bio.v14i2.4839
 Abstract View: 342,
Abstract View: 342,
 PDF Download: 319
PDF Download: 319
-
Tinjauan Literatur tentang Penggunaan E-Modul sebagai Media Pembelajaran Biologi
 DOI :
https://doi.org/10.56013/bio.v14i2.4845
DOI :
https://doi.org/10.56013/bio.v14i2.4845
 Abstract View: 976,
Abstract View: 976,
 PDF Download: 613
PDF Download: 613